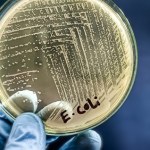
​Sześć miejscowości bez wody. To kolejny taki przypadek na Dolnym Śląsku

wodociąg
- Wszystkie (70)
- Artykuły (70)
Artykuły (70)
-
Sześć miejscowości bez wody. To kolejny taki przypadek na Dolnym Śląsku
- Środa, 22 października (18:13)
-
Awaria w Warszawie. Woda zalała drogę
- Piątek, 10 stycznia (08:59)
Awaria wodociągu w centrum Warszawy. Do usterki doszło przy skrzyżowaniu ul. Świętokrzyskiej z ul. Czackiego.Warszawa, wodociąg -
Szczecin: Awaria wodociągu wstrzymała tramwaje
- Wtorek, 7 stycznia (17:26)